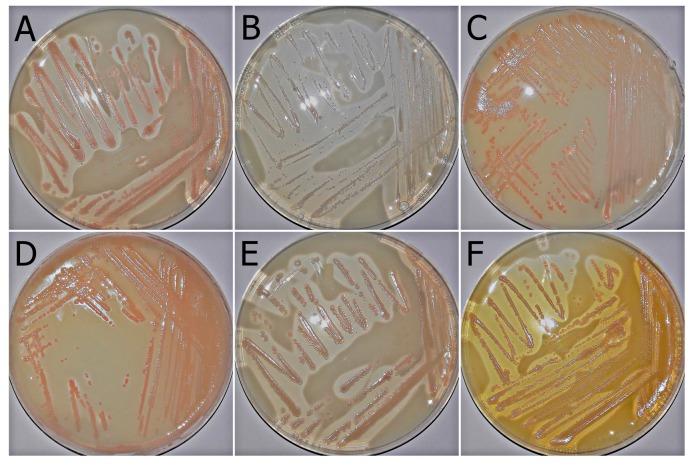
https://cdn.ncbi.nlm.nih.gov/pmc/blobs/fce1/6151773/06f84203455b/molecules-22-01608-g003.jpg

鉴定拉恩氏菌(Asaia lannensis)和博尔加氏菌(Asaia bogorensis)中的类胡萝卜素和异戊二烯醌。
Identification of Carotenoids and Isoprenoid Quinones from Asaia lannensis and Asaia bogorensis.
机构信息
Institute of Fermentation Technology and Microbiology, Faculty of Biotechnology and Food Science, Lodz University of Technology, 171/173 Wólczańska, 90-924 Lodz, Poland.
Institute of Food Technology and Analysis, Faculty of Biotechnology and Food Science, Lodz University of Technology, 4/10 Stefanowskiego, 90-924 Lodz, Poland.
出版信息
Molecules. 2017 Sep 25;22(10):1608. doi: 10.3390/molecules22101608.
The aim of the study was to identify and quantitatively assess of carotenoids and isoprenoid quinones biosynthesized by six different strains of acetic acid bacteria, belonging to genus , that are common beverage-spoiling bacteria in Europe. Bacterial cultures were conducted in a laboratory liquid culture minimal medium with 2% sucrose. Carotenoids and isoprenoid quinones were investigated using UHPLC-DAD-ESI-MS analysis. In general, tested strains of spp. were able to produce 10 carotenoids and 3 isoprenoid quinones: menaquinone-7, menaquinone-8, and ubiquinone-10. The main identified carotenoids in strains were phytofluene, neurosporene, α-carotene, while for , neurosporene, canthaxanthin, and zeaxanthin were noted. What is more, tested spp. were able to produce myxoxanthophyll, which has so far been identified primarily in cyanobacteria. The results show that are characterized by statistically higher concentrations of produced carotenoids, as well as a greater variety of these compounds. We have noted that carotenoids were not only accumulated by bacterial cells, but also some strains of produced extracellular carotenoids.
本研究旨在鉴定并定量评估 6 株不同的醋酸菌属( )菌株合成的类胡萝卜素和类异戊二烯醌,这些菌株是欧洲常见的饮料腐败菌。在含有 2%蔗糖的实验室液体培养基础培养基中进行细菌培养。采用 UHPLC-DAD-ESI-MS 分析方法研究类胡萝卜素和类异戊二烯醌。一般来说,测试的 菌株能够产生 10 种类胡萝卜素和 3 种类异戊二烯醌:甲萘醌-7、甲萘醌-8 和泛醌-10。在 菌株中主要鉴定出的类胡萝卜素为叶黄质、神经鞘氨醇、α-胡萝卜素,而在 中则为神经鞘氨醇、斑蝥黄质和玉米黄质。此外,测试的 菌株能够产生迄今为止主要在蓝细菌中鉴定出的菌叶黄素。研究结果表明, 属的菌株具有统计学上更高的类胡萝卜素产量,以及更多种类的类胡萝卜素。我们注意到,类胡萝卜素不仅被细菌细胞积累,而且一些 菌株还产生细胞外类胡萝卜素。